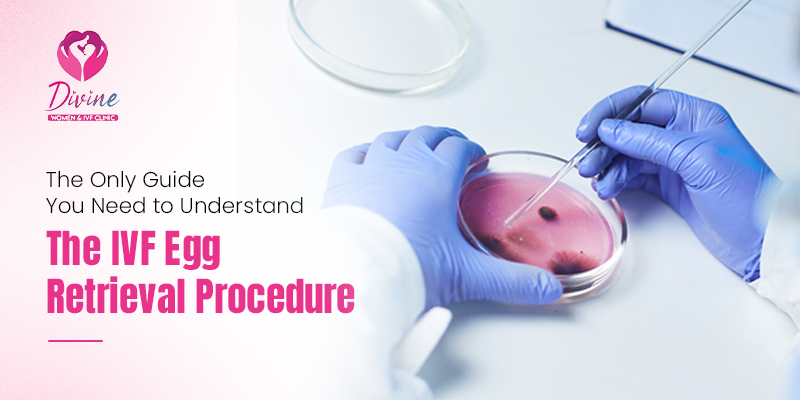
IVF egg retrieval

Get Online consultation with 3 Easy Process
- Pay Consultation Fee (RS.1000) by using QR Code
- Send payment screenshot on whats app: +91 9910873175
- After Verifying Your Payment, We Will connect you with doctor

Table of Contents
For many couples desiring a baby, waiting can be a time of stress. The passing of every month may feel heavier, as every little sign brings hope or worry. When this happens, IVF becomes a source of support that many turn to with care. One key step in this treatment is called IVF egg retrieval. It is the stage that helps doctors collect mature eggs for fertilisation in a safe and planned way. Understanding this step can help reduce fear and make the process easier to follow. In this blog, we will guide you gently so you feel prepared and informed.
1. Your body is given special medicines that help grow several eggs at the same time. Your doctor keeps a close eye on your progress through simple scans and blood tests.
2. When the eggs are fully ready, your doctor gives a final trigger shot. This helps the eggs reach the right stage for collection during the procedure.
3. The IVF egg retrieval step is done in a clinic room while you rest under light sedation. A thin needle is used to collect the eggs from the ovaries. This process usually takes less than thirty minutes and is not painful because you will be relaxed.
4. After the eggs are collected, they are taken to the lab where experts check their quality. Then the eggs are used for fertilisation to start the next step of treatment.
Good preparation will make the procedure of IVF egg retrieval easier. Firstly, discuss every stage of the process with your doctor in detail so that you are prepared. Drink ample water and eat simple meals as instructed during your medicine cycle. You may be advised to avoid certain items, like strong coffee or some tablets, before the procedure. Have a good sleep the night before, and follow the timing of the trigger shot very precisely. On the day of the procedure, wear loose, comfortable clothes. Bring a family member with you so that you can feel supported and safe. After the procedure, you may feel mild cramps, but these usually settle in a short time.
Understanding the steps of the IVF egg retrieval process can help reduce much of the stress caused by treatment. The more aware you are of how it works, the more in control you are and less frightened by what’s in store. The procedure is safe, quick, and planned in such a way to protect your comfort at every step. Talk to your doctor, heed the advice given, and take care of your preparation with calmness. With the right support, this step can bring you closer to your dream and give you new hope.
If you are looking for trusted care, Dr. Mandavi Rai is one of the best fertility doctors. We work every day to give patients clear guidance and gentle care. We support them at every step so that they may feel safe and supported. Our team makes sure each person understands the process in simple words and feels heard during treatment. We focus on comfort, trust, and careful planning, which helps make the IVF experience smoother for couples who come to us with hope in their hearts.
1. What happens to the eggs after they are collected?
They are checked in the lab and then used for fertilisation. This helps start the next step.
2. Is the retrieval process painful?
Most people do not feel pain because they rest under light sedation. Most feel fine soon after.
3. How long does recovery take?
Most people feel normal in a day and can return to simple tasks. Your doctor will guide you.
4. How many eggs are usually collected?
This depends on age and body response, but doctors aim for several mature eggs. Each case is different, though.
[…] “Also Read”- https://drmandaviraiivfspecialist.com/the-only-guide-you-need-to-understand-the-ivf-egg-retrieval-pr… […]